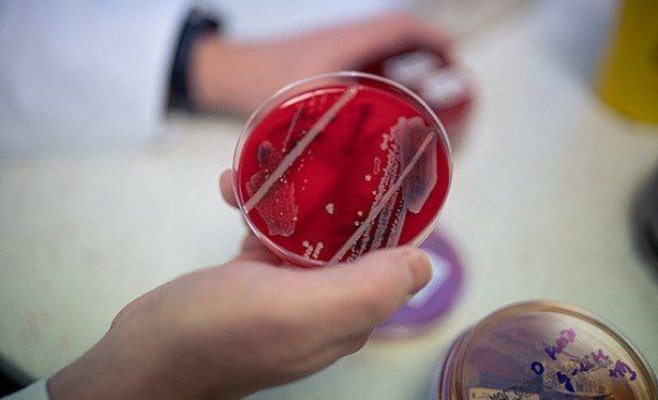
Тихая пандемия угрожает всем. Устойчива к антибиотикам

Посадите новое дерево или заплатите. Министерство планирует изменить правила вырубки деревьев в городах
Популярное
Деревья в городах и поселках должны быть более защищены. Государство хочет, чтобы люди, компании и учреждения сажали новые деревья, а не вырубали их. Если это невозможно, они должны будут платить новый сбор. Власти предлагают это сделать в рамках готовящейся поправки к Закону об охране природы и ландшафтов.
Действующий закон уже обязывает застройщиков заменять вырубленные деревья новыми или выплачивать денежную компенсацию. Однако сумма не определена ни в одном нормативном акте. На практике финансовая компенсация не применяется.
Именно поэтому министерство считает существующие правила недостаточными. "В условиях продолжающегося изменения климата, последствия которого для окружающей среды становятся все сильнее, необходимо обеспечить достаточную защиту деревьев, растущих вне лесов, особенно деревьев, растущих в городах, где их значение для человека и городской среды обитания совершенно незаменимо", - заявили в ведомстве, объясняя, почему оно хочет более строго соблюдать новые правила.
Новые правила распространяются на деревья, для вырубки которых требуется разрешение. Речь идет о тех деревьях, окружность ствола которых достигает не менее 80 сантиметров на высоте 1,3 метра над землей. Приоритет отдается замещающим посадкам и последующему уходу, который будет возложен на людей и компании в течение пяти лет. В случае невозможности посадки деревьев в радиусе километра от границы участка взимается плата.
До 100 000 за срубленное дерево
Конкретная сумма будет зависеть от размера дерева, его состояния и значимости. Она будет варьироваться от сотен крон до более чем 100 000 за срубленное дерево. По оценкам властей, средняя сумма составит около 31 500. Ежегодный сбор составит 551 миллион. Эти деньги пойдут муниципалитетам, которые будут использовать их, например, для покрытия расходов, связанных с дальнейшей посадкой деревьев.
Деревья в городах помогают охлаждать улицы, удерживают воду, дают кров и пищу животным. По данным CENIA, площадь деревьев в городах с населением более 20 000 человек в период с 2017 по 2020 год сократилась с примерно 120 000 до менее чем 94 000 гектаров. Более свежие данные пока не доступны.
В итоге министерство остановилось на варианте, при котором сборы будут взимать муниципалитеты, а не строительные органы. Таким образом, строители должны будут уведомлять не то учреждение, в которое они обращаются за разрешением на строительство. По мнению предпринимателей, это может привести к дальнейшим задержкам в процедуре строительства.
"Печально, что вместо того, чтобы упростить и ускорить процедуру строительства, государство делает ее более сложной, долгой и дорогой. И в случае со строительством для государственных инвесторов, которых, я думаю, будет большинство, мы все будем платить за это. Что касается частного сектора, то за него будет платить только кто-то один", - сказал Йиржи Ноуза, президент Союза предпринимателей строительной отрасли.
На вопрос Новинека в министерстве ответили, что отдельное разбирательство, связанное с платой, будет касаться лишь десятой части случаев, когда количество вырубаемых деревьев будет уменьшено по сравнению с уже разрешенным планом. "В большинстве случаев застройщик воспользуется институтом так называемой самооценки сбора и лишь уведомит компетентный орган охраны природы о начале вырубки за 30 дней", - сказала Вероника Крейчи, пресс-секретарь ведомства.
По ее словам, преимущество этой процедуры заключается в том, что люди и компании будут платить только за фактически вырубленные деревья, и им не придется подавать заявление на изменение разрешения на строительство из-за корректировки суммы сбора.